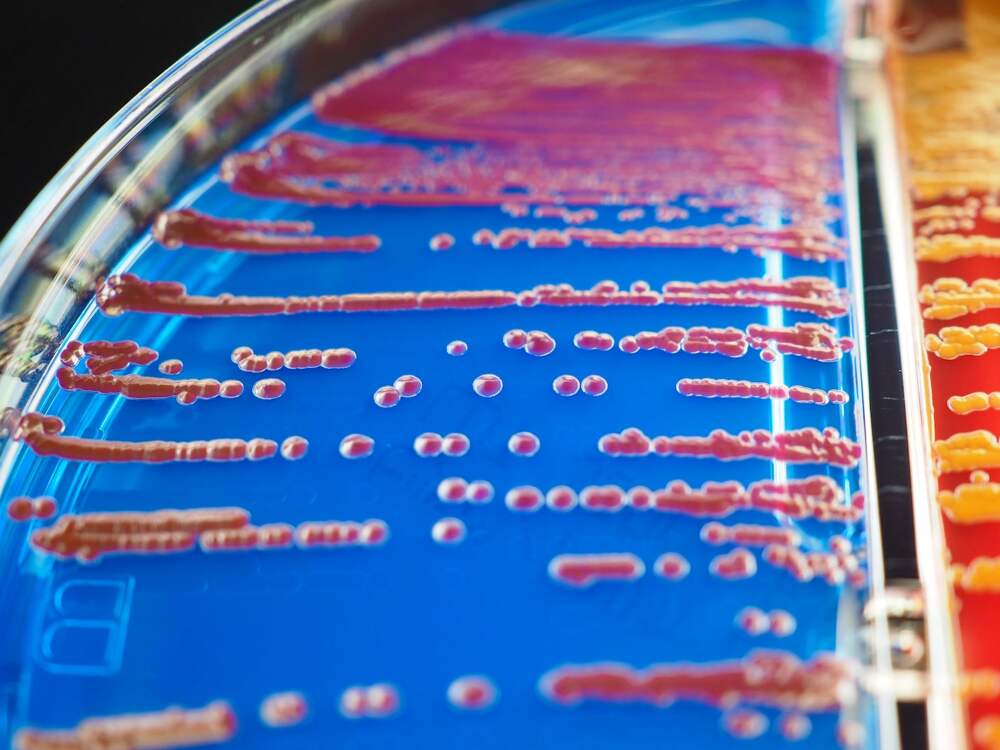

How to Build Better Digital Twins of the Human Brain
Brain twins where regions are allowed to compete for resources behave more like the real thing. The potential to create personalized digital twins of your brain and body is a hot topic in neuroscience and medicine today. These computer models are designed to simulate how parts of your brain... Далее